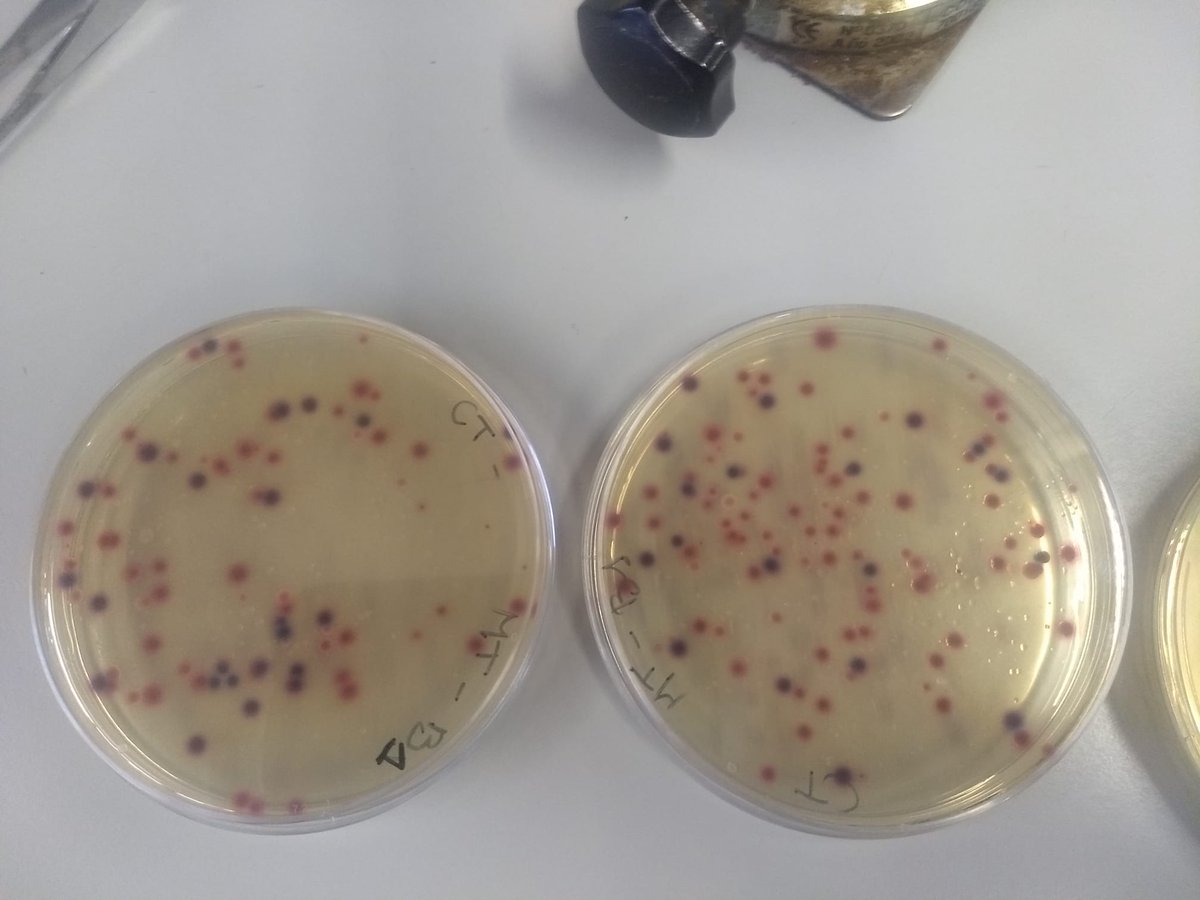
Elisenda tweet media

Sabitlenmiş Tweet

Anna Sanchez Vidal@aneguet77
📢New Publication! "The dark side of artificial greening: Plastic turfs as widespread pollutants of aquatic environments"🌿 We have found that artificial turf fibers account for up to 15% of the meso- and macroplastics in rivers and sea surface waters! doi.org/10.1016/j.envp…
QME